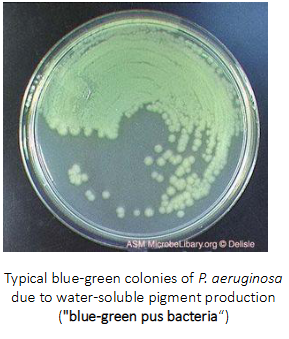
<p>Pseudomonas aeruginosa</p>

1/19
Looks like no tags are added yet.
Name | Mastery | Learn | Test | Matching | Spaced | Call with Kai |
|---|
No analytics yet
Send a link to your students to track their progress
Pathogens, Pathogenicity and Virulence
PATHOGEN: any microorganism that has the capacity to cause disease
Virulence is measure of 'pathogenicity' or the likelihood that a microorganism will cause disease after infecting someone
- Principal pathogens may cause heart disease in the presence of an intact immune system (highly virulent)
- Opportunist pathogens only cause disease in those with underlying disease or compromised immune system (less virulent)

Gram negative bacteria chart
DIAGRAM ON SLIDE 4


Classification of medically important Gram-negative bacteria
DIAGRAM ON SLIDE 5


Vibrio Cholerae
- Disease of antiquity

Vibrio Cholerae - Clinical Features and Burden
- Very severe watery diarrhoea: 'rice water stool' (death due to dehydration or electrolyte imbalance)
ANNUAL BURDEN OF DISEASE
- 3-5 million cases
- 100,000 deaths
- Most cases and deaths in Africa

Disease is a result of host-pathogen-environment interaction e.g cholera
INFECTING AGENT: Vibrio Cholerae
- virulence factors (toxin genes, pilus)
- inoculum (size of the infecting dose - 10^8)
.
HOST:
- genetic (ABO blood group)
- immune status
- gastric acidity
.
ENVIRONMENT:
- climate
- sanitation and water supply

Environmental factors and cholera
Environmental niche is saline coastal waters and estuaries
- Lives in biofilm on zooplankton and shellfish
- During periods of nutrient deficiency -> viable, non-culturable form in biofilms
- Favourable conditions (zooplankton bloom) -> proliferate -> humans ingest water
.
- once in humans, outbreaks occur through faecal contamination of water supply

V. chloerae virulence factors
- colonises the gut mucosa, doesnt invade
- Flagellum moves the bacteria towards the epithelial surface
- Cholera toxin coregulated pilus (TcpA) mediates attachment to mucosa, cholera toxin causes diarrhoea
- How did environmental organisms become pathogenic to humans?
.
Non-pathogenic strains were infected by a bacteriophage: Vibrio Pathogenicity Island phage - VPI(phi)"


Need to know:
Gram stain, morphology, but not biochemical tests of the bolded pathogens on diagram


Family: Enterobacteriaceae
- facultative anaerobes (microorganism that can reproduce and survive both inside a host (causing disease) and in external environmental reservoirs like soil or water)
- Simple nutritional requirements - ferment glucose and other carbohydrates
- Often motile with peritrichous flagella
- Inhabit intestinal tracts of humans, animals
- Includes some common and important pathogens


Enterobacteriae: Salmonella enterica
- Salmonella infections are typically acquired by eating contaminated food or via person to person spread
TYPHOIDAL SEROTYPES of Salmonella enterica (human pathogens only):
- Humans may be asymptomatic carriers
- Cause 'enteric fever' (typhoid) - serious illness with bacteraemia
- Salmonella Typhi (actually S. enterica subsp. enterica, serovar Typhi)
- Salmonella Paratyphi types A, B and C
.
NON-TYPHOIDAL SEROTYPES of Salmonella enterica
- commensals of various animal species (acquired by eating contaminated food)
- Usually self-limiting diarrhoea in humans
- Can cause disseminated disease in human immune-compromised people


Salmonella Infections and One Health
- Multi-resistant Salmonella infections are a major public health threat
- Antimicrobial resistance in Salmonella spreads through humans, the food chain and the environment
- One Health is an integrated, unifying approach that aims to sustainably balance and optimise the health of people, animals and ecosystems


Enterobacteriaceae: Escherichia coli
- One of the most common inhabitants of the human GI tract
- Commensal, not usually a pathogen
- the best studied bacterium - genetics, physiology, molecular biology
- Pathogenic strains are grouped according to their virulence factors/diseases


Enterobacteriaceae: Escherichia coli (Enterohemorrhagic E. coli)
- the table basically shows that E. coli engages in a lot of horizontal gene transfer and therefore gets these virulence factors


Livestock feeding practices affect human health (e.g E. coli 0157:H7 and cattle feeding)
- Approx. 30% of feedlot cattle are reservoirs of E. coli strain O157: H7
- Feedlot cattle are fed high grain rations to increase feed efficiency: 'grain finished' beef
- High grain rations -> some starch escapes ruminal microbial degredation and passes to the hindgut -> fermented by E. coli)
- Total E. coli is higher in grain-fed than in grass-fed cattle: when cattle are switched from a high grain diet to an all hay diet, E. coli populations decline 1000-fold
- 'grain finishing' increases risk of human infection with pathogenic E. coli strains, which can cause renal failure
- Outbreaks associated with petting zoos, contaminated vegetables or meat

Pseudomonas aeruginosa
WIDELY DISTRIBUTED IN SOIL, WATER, PLANTS, GUT OF HUMANS AND ANIMALS
- Generally regarded as ubiquitous in soil and water environments, but is rarely found in pristine ecosystems
- Mostly detected in habitats contaminated by human activity, (human and animal faeces are important reservoirs)
.
RESERVOIRS IN URBAN COMMUNITIES:
- Include hot tubs, jacuzzis, swimming pools
.
RESERVOIRS IN HOSPITRALS:
- water distribution systems, sinks, plumbing, disinfectant solutions
.
- importance as a human pathogen did not emerge until the second half of the 20th century
- often multi-drug resistant


P. aeruginosa infections in healthy patients
- P. aeruginosa can cause infections in those with an intact immune system (shown here), but infections are more common in individuals with an immunocompromised state


P. aeruginosa infections in immune compromised patients
- Cystic fibrosis - chronic lung infection occurs in over 60% of adults with CF - linked to higher mortality
- Burn wound infections - a blue-green purulent discharge may be found
- Diabetes - malignant otitis externa
.
OFTEN HEALTHCARE ASSOCIATED:
- Organ transplant recipients or ICU patients - pneumonia, urinary tract infections, bacteraemia
- Invasive diseases, e.g indwelling catheters or endotracheal tubes - at risk due to ability to fom biofilms


Biofilms: stages of biofilm formation and dispersal
- remember quorum sensing: this plays a role int he change from biofilm-associated to planktonic lifestyle in bacteria
.
A biofilm is a structured community of microorganisms—such as bacteria, fungi, or algae—enclosed in a self-produced slimy, protective matrix (extracellular polymeric substance) that adheres to living or non-living surfaces


Healthcare-associated (nosocomial) infections
- Acquired as a direct or indirect result of healthcare
- Bloodstream, pneumonia, urinary tract infections are most common
- Any healthcare setting: hospitals, general practice clinics, dental clinics, community health facilities, long-term care facilities
- Many gram-negative bacilli are common causes, particularly: Klebisella spp, Pseudomonas spp, Acinetobacter spp
- Methicillin-resistant S. aureus also often multidrug resistant
